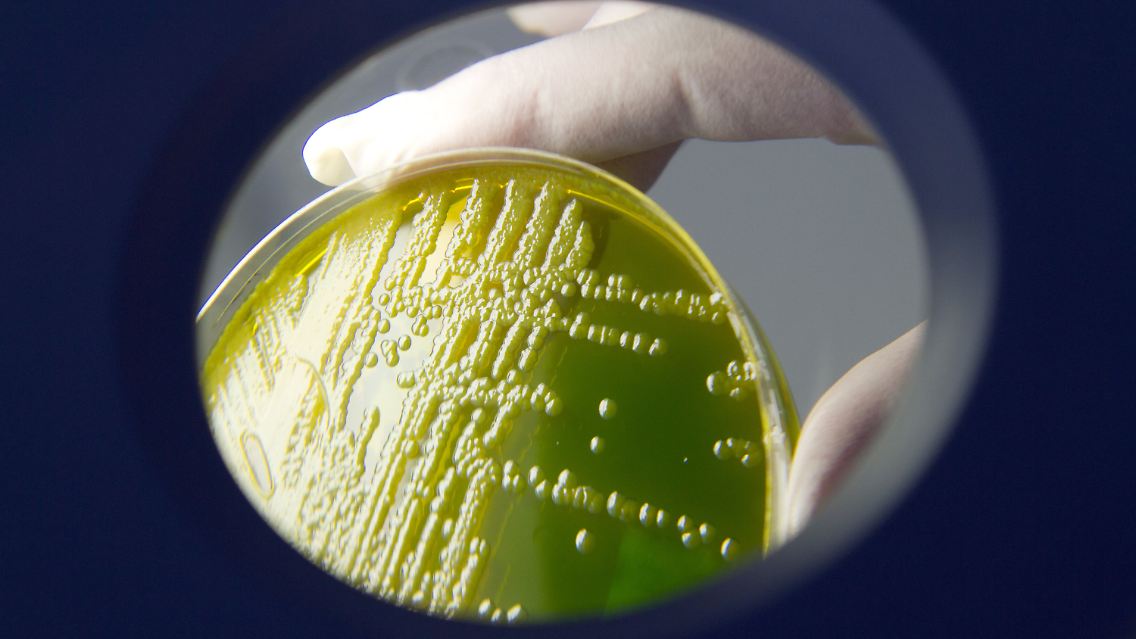

EHEC-Infektionswelle hält an Bund beruft Krisentreffen ein
29.05.2011, 17:02 UhrOffiziell soll es ein "Informationsgespräch" zwischen den zuständigen Ministerien und Gesundheitsexperten sein, doch die ernste Lage legt nahe, dass am Montag in Berlin ein Krisenstab zur EHEC-Welle tagt. Der Erreger ist noch immer nicht zweifelsfrei lokalisiert, wieder taucht infizierte Ware auf. Bislang sind 1200 Infizierte und Verdachtsfälle registriert.
Eine Laborantin des Robert-Koch-Instituts vergleicht EHEC-Kolonien auf Nährboden.
(Foto: dpa)
Bundesregierung, Länder und Behörden wollen die Ausbreitung der EHEC-Welle an diesem Montag in einem Spitzentreffen in Berlin beraten.
Die Lage erörtern wollen Verbraucherministerin Ilse Aigner, Gesundheitsminister Daniel Bahr, die Präsidenten des Robert Koch-Instituts, des Bundesinstituts für Risikobewertung, des Bundesamts für Verbraucherschutz und Lebensmittelsicherheit sowie die Vorsitzenden der Länderministerkonferenzen für Gesundheit, für Verbraucher und Agrar sowie die Hamburger Gesundheitssenatorin Cornelia Prüfer-Storcks.
Es sei ein "Informationsgespräch" über den Stand der wissenschaftlichen Untersuchungen und "die getroffenen Maßnahmen im Zusammenhang mit HUS-Erkrankungen", sprich die schweren Fälle, teilte die Bundesregierung mit.
EHEC noch nicht unter Kontrolle
Der Stand der Dinge lässt eher darauf schließen, dass es sich um ein Krisentreffen handelt. Von einer Kontrolle der EHEC-Infektionswelle kann bisher keine Rede sein. Täglich mehr Kranke und langsam, aber kontinuierlich steigende Totenzahlen lassen Ängste wachsen. Von den rund 80 am Hämolytisch-Urämischen Syndrom erkrankten Patienten am Hamburger Uniklinikum Eppendorf haben etwa 30 keine Nierenfunktion mehr. Weil der Platz zur Behandlung der HUS-Kranken schwindet, hat das Krankenhaus nach Angaben einer Sprecherin bereits weniger schwer erkrankte Patienten an andere Kliniken überstellt. Deutschlandweit wurden mittlerweile mehr als 1200 bestätigte und EHEC-Verdachtsfälle registriert, in Hamburg bis Samstag 467. Der Ernstfall ist da - und es zeigt sich, wie schwer es ist, EHEC in Grenzen zu halten.
Anders als bei vielen anderen Erregern reichen wenige EHEC-Keime für eine Infektion. Doch woher die Erreger jetzt zu ihren Opfern kommen, ist unklar. "Die Quelle des Ausbruchs ist noch nicht gesichert", stellt die EU-Seuchenkontrollbehörde ECDC fest. Mit Blick auf die EU insgesamt schreiben die obersten Seuchenwächter: "Das genaue Ausmaß des Ausbruchs wird wahrscheinlich in den kommenden Wochen deutlich."
Helge Karch stöhnt: "So etwas gab es bisher noch nie." Der führende Mikrobiologe für EHEC meint in der "Frankfurter Allgemeinen Sonntagszeitung": "Wenn so viele Menschen täglich erkranken, so ist der doch hochgefährlich!"
EHEC-Gurken in MV festgestellt

Die Warnungen vor Gurken und anderem Gemüse sind schlecht fürs Geschäft.
(Foto: dpa)
Offensichtlich sind die Keime schneller als ihre Jäger. Bei drei Gurken, die in Lebensmittelläden und Gaststätten Mecklenburg-Vorpommerns sichergestellt wurden, haben Kontrolleure des Landes Hinweise auf das gefährliche EHEC-Bakterium gefunden. Der Erreger selbst sei allerdings noch nicht nachgewiesen worden, teilte Verbraucherschutzminister Till Backhaus mit. Der Test werde mindestens bis Mitte der Woche dauern. Zum Herkunftsland der Gurken machte Backhaus keine Angaben.
Das Robert-Koch-Institut hatte die Erreger auf spanischen Salatgurken gefunden. Seitdem lassen die Verbraucher die Finger von spanischer Rohkost, der Handel mit Deutschland ist komplett eingebrochen. Die iberischen Hersteller sind stocksauer und fühlen sich als Opfer in der "Gurkenkrise". Solange der Erreger nicht zweifelsfrei lokalisiert wurde, hält die Verbraucherschutzministerin an der Warnung vor dem Verzehr roher Gurken, Blattsalaten und ungekochter Tomaten fest.
EHEC seit 1982 bekannt
Erstmals erkannt wurde EHEC 1982 in den USA - in Deutschland gab es bereits mehrere Ausbrüche. In einer Antwort auf eine kleine Anfrage der Grünen im Bundestag erläuterte das Gesundheitsministerium 1998 die Forschungen zu dem Bakterium. Auch der Hinweis findet sich: "Der über die Routinediagnostik und die institutionelle Forschung hinausgehende Forschungsbedarf muss entsprechend den finanziellen Möglichkeiten eingeordnet werden." Auch von großer epidemiologischer und diagnostischer Unsicherheit ist die Rede.
Quelle: ntv.de, dpa











